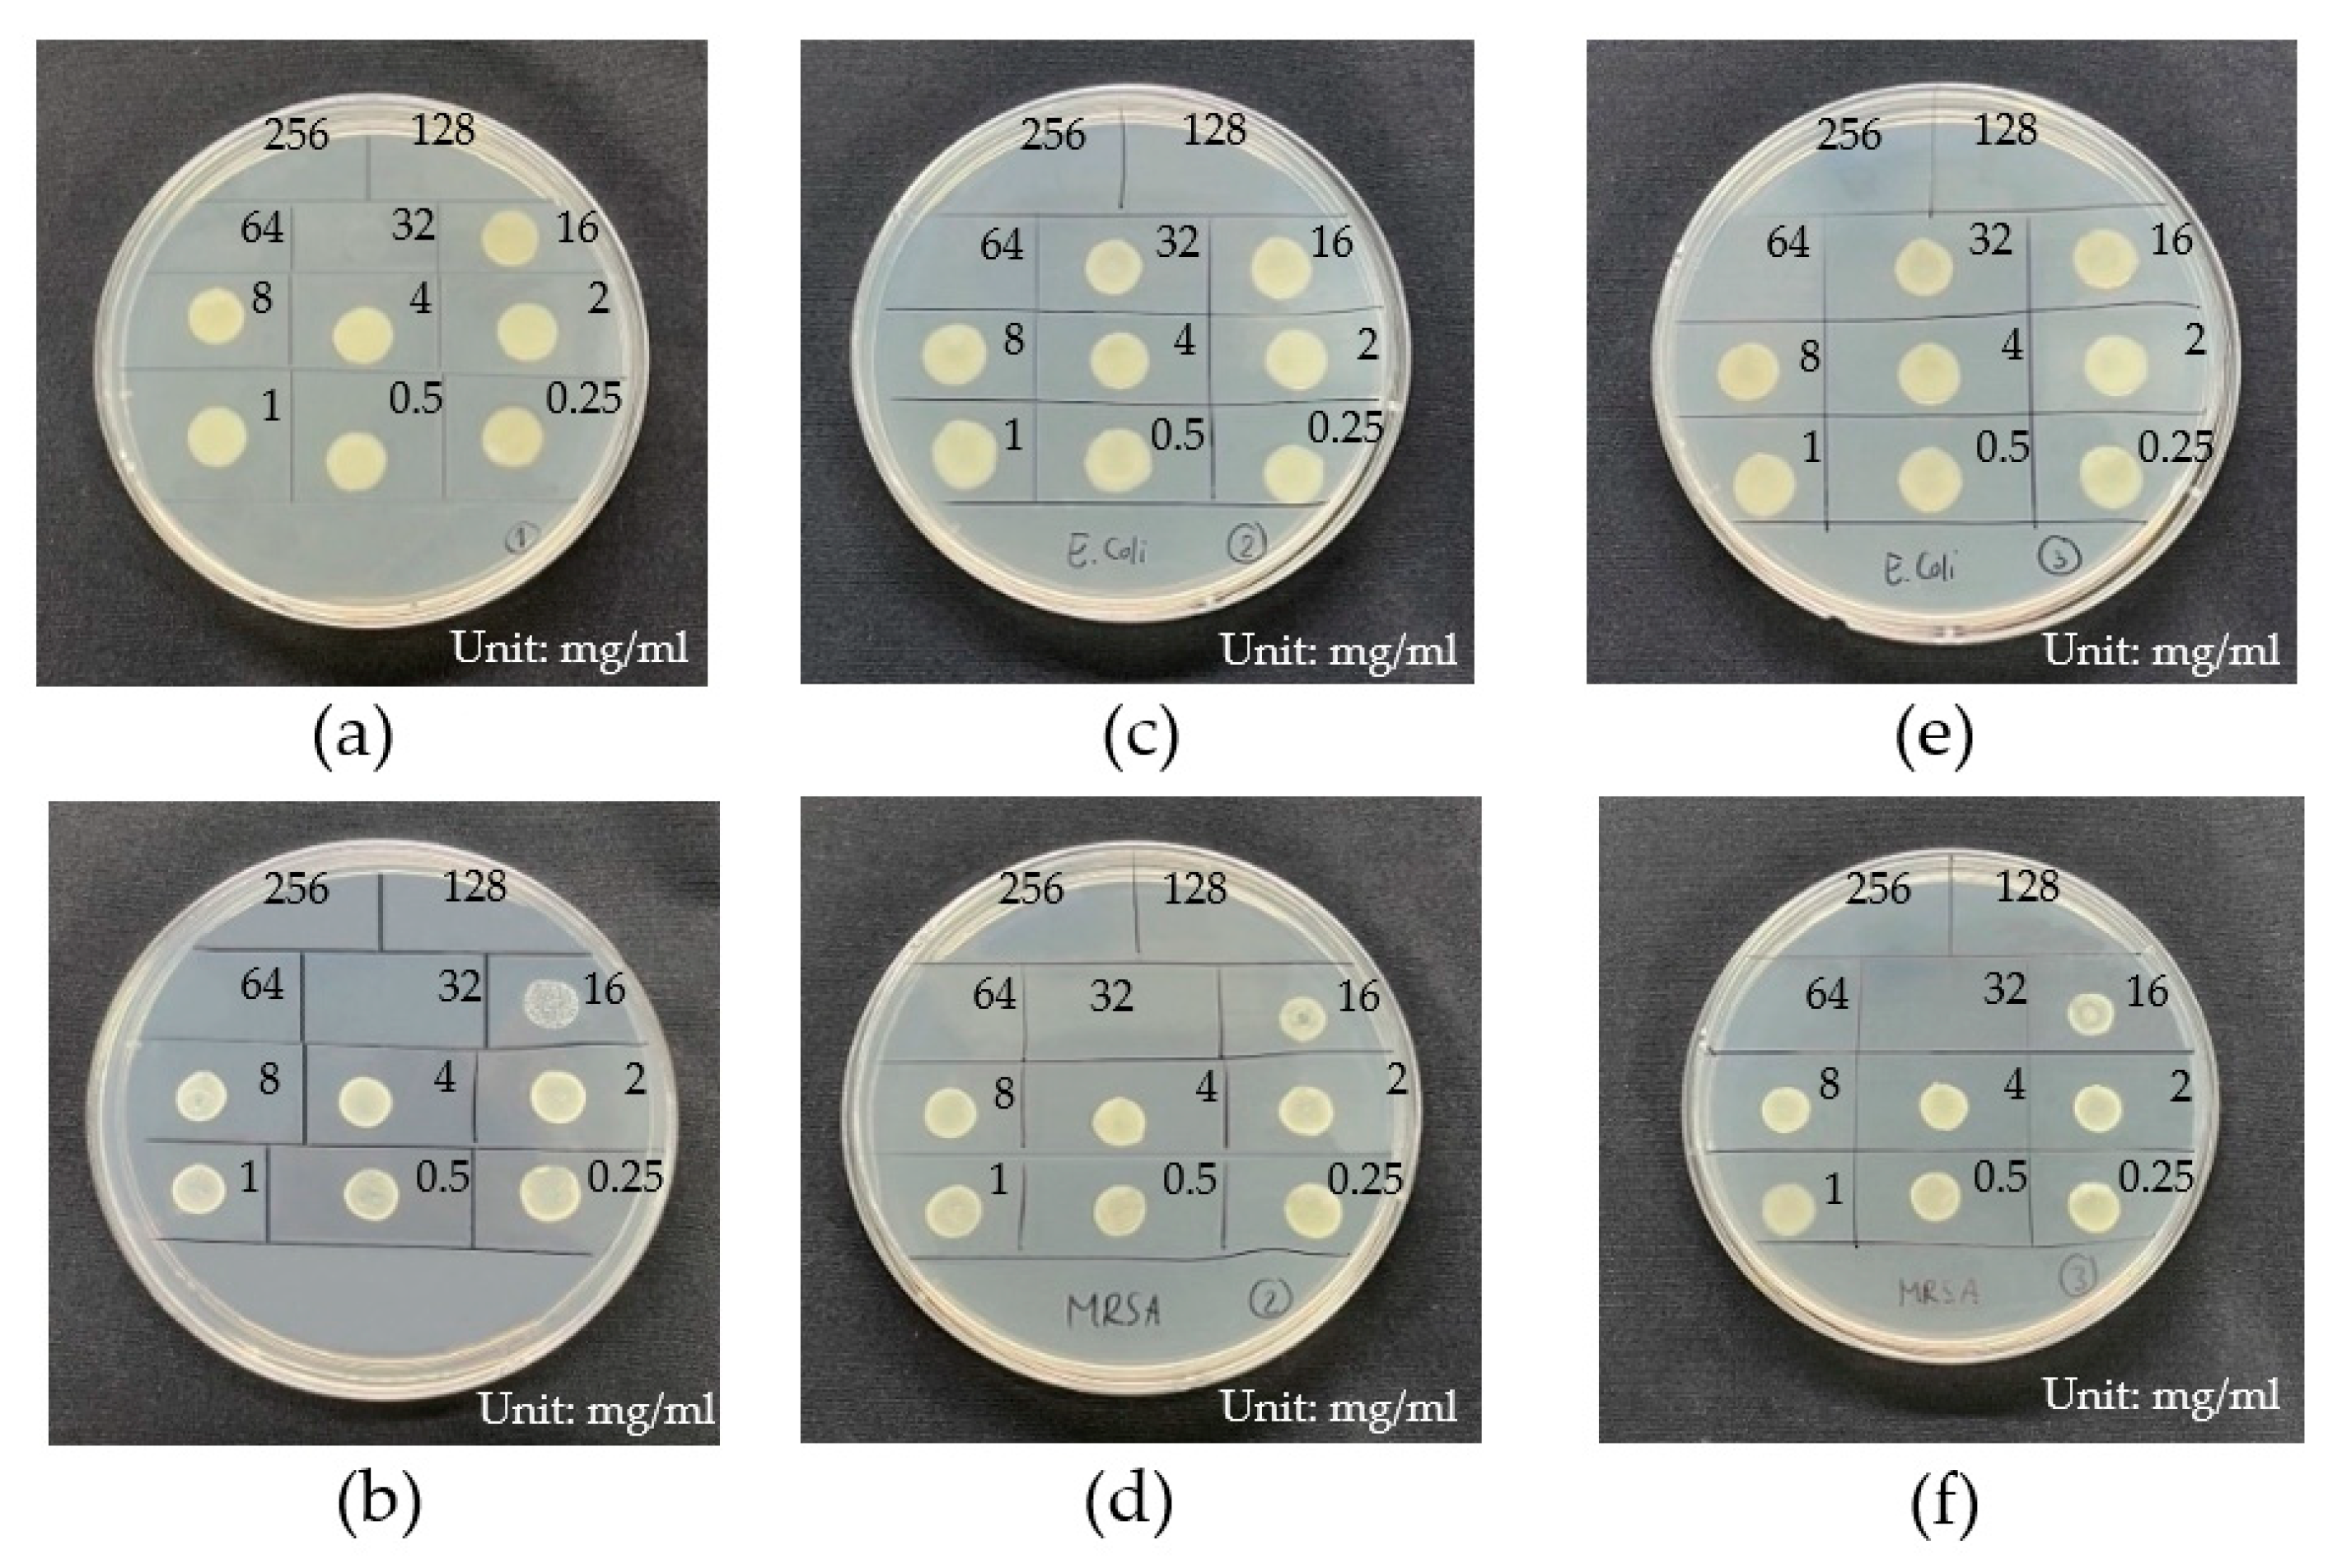
Gels 09 00053 g007 Gels 09 00053 g007

Curative Effects of Copper Iodide Embedded on Gallic Acid Incorporated in a Poly(vinyl alcohol) (PVA) Liquid Bandage
Abstract
1. Introduction
2. Results and Discussion
2.1. Encapsulation and Stabilization of Gallic Acid–Cuprous Iodide Nanoparticles
2.1.1. X-ray Diffraction (XRD) Analysis
- t = crystallite size;
- K = shape factor (0.9);
- λ = wavelength of x-ray (0.154 nm);
- β = full width at half maximum (FWHM);
- ϴ = diffraction angle.

2.1.2. X-ray Photoelectron Spectroscopy (XPS) Study
2.1.3. Field Emission Scanning Electron Microscope (FESEM) Analysis of CuI
2.1.4. Fourier Transform Infrared Spectrum (FTIR)
2.1.5. Zeta Potential Analysis
2.1.6. Nanosizer/Dynamic Light Scattering
2.1.7. Peroxidase-like Properties of GA-CuI NPs
2.1.8. Evaluation of Minimum Inhibitory Concentration (MIC) and Minimum Bactericidal Concentration (MBC) of CuI NPs
2.2. PVA/CuI Liquid Bandage Formulation
2.2.1. Fourier Transform Infrared Spectroscopy (FTIR)
2.2.2. Surface Morphology Analysis of Cast PVA Film Using Field Emission Scanning Electron Microscopy (FESEM)
2.2.3. Swelling Behavior of Pure PVA and PVA/CuI Film
2.2.4. Drying Time of PVA Liquid Bandages
2.2.5. Water Vapor Transmission Rate (WVTR)
2.2.6. In Vitro Cytotoxicity and Biocompatibility of Liquid Bandage
2.2.7. Antibacterial Efficacy Testing by Time–Kill Assay
3. Conclusions
4. Materials and Methods
4.1. Materials
4.2. Preparation of Gallic Acid–Cuprous Iodide Nanoparticles
4.3. Preparation of PVA Antibacterial Liquid Dressing with Additional Gallic Acid–Cuprous Iodide
4.4. Crystal Structure of CuI NPs
4.5. Characterization of Microstructure and Morphology of Synthesized CuI NPs and PVA Liquid Bandage
4.6. Functional Group Determination of CuI NPs and PVA Liquid Bandage
4.7. Size Determination of CuI NPs
4.8. Peroxidase-like Activity of CuI NPs
4.9. Evaluation of Minimum Inhibitory Concentration (MIC) and Minimum Bactericidal Concentration (MBC) of CuI NPs
4.10. Physical Properties of PVA Liquid Bandage Formulation
4.11. In Vitro Indirect Cytotoxic Test of PVA Liquid Bandage Formulations
4.12. Antibacterial Test by Time–Kill Assay
Author Contributions
Funding
Data Availability Statement
Acknowledgments
Conflicts of Interest
Declaration of Competing Interest
References
- Alven, S.; Aderibigbe, B.A. Fabrication of Hybrid Nanofibers from Biopolymers and Poly (Vinyl Alcohol)/Poly (ε-Caprolactone) for Wound Dressing Applications. Polym. J. 2021, 13, 2104. [Google Scholar] [CrossRef] [PubMed]
- Li, S.; Dong, S.; Xu, W.; Tu, S.; Yan, L.; Zhao, C.; Ding, J.; Chen, X. Antibacterial Hydrogels. Adv. Sci. (Weinh.) 2018, 5, 1700527. [Google Scholar] [CrossRef] [PubMed]
- Rezvani Ghomi, E.; Khalili, S.; Nouri Khorasani, S.; Esmaeely Neisiany, R.; Ramakrishna, S. Wound dressings: Current advances and future directions. J. Appl. Polym. Sci. 2019, 136, 47738. [Google Scholar] [CrossRef]
- Kalantari, K.; Mostafavi, E.; Saleh, B.; Soltantabar, P.; Webster, T.J. Chitosan/PVA hydrogels incorporated with green synthesized cerium oxide nanoparticles for wound healing applications. Eur. Polym. J. 2020, 134, 109853. [Google Scholar] [CrossRef]
- Chopra, H.; Bibi, S.; Kumar, S.; Khan, M.S.; Kumar, P.; Singh, I. Preparation and Evaluation of Chitosan/PVA Based Hydrogel Films Loaded with Honey for Wound Healing Application. Gels 2022, 8, 111. [Google Scholar] [CrossRef] [PubMed]
- Yudaev, P.; Mezhuev, Y.; Chistyakov, E. Nanoparticle-Containing Wound Dressing: Antimicrobial and Healing Effects. Gels 2022, 8, 329. [Google Scholar] [CrossRef] [PubMed]
- Mei, L.; Lu, Z.; Zhang, X.; Li, C.; Jia, Y. Polymer-Ag Nanocomposites with Enhanced Antimicrobial Activity against Bacterial Infection. ACS Appl. Mater. Interfaces 2014, 6, 15813–15821. [Google Scholar] [CrossRef]
- Mei, L.; Xu, Z.; Shi, Y.; Lin, C.; Jiao, S.; Zhang, L.; Li, P. Multivalent and synergistic chitosan oligosaccharide-Ag nanocomposites for therapy of bacterial infection. Sci. Rep. 2020, 10, 10011. [Google Scholar] [CrossRef]
- El-Sherif, H.; El-Masry, M.; Kansoh, A. Hydrogels as template nanoreactors for silver nanoparticles formation and their antimicrobial activities. Macromol. Res. 2011, 19, 1157. [Google Scholar] [CrossRef]
- Lee, J.W.; Choi, S.-R.; Heo, J.H. Simultaneous Stabilization and Functionalization of Gold Nanoparticles via Biomolecule Conjugation: Progress and Perspectives. ACS Appl. Mater. Interfaces 2021, 13, 42311–42328. [Google Scholar] [CrossRef]
- Sánchez-Sanhueza, G.; Fuentes-Rodríguez, D.; Bello-Toledo, H. Copper Nanoparticles as Potential Antimicrobial Agent in Disinfecting Root Canals: A Systematic Review. Int. J. Odontostomatol. 2016, 10, 547–554. [Google Scholar] [CrossRef]
- Sunada, K.; Minoshima, M.; Hashimoto, K. Highly efficient antiviral and antibacterial activities of solid-state cuprous compounds. J. Hazard. Mater. 2012, 235–236, 265–270. [Google Scholar] [CrossRef] [PubMed]
- Thurman, R.B.; Gerba, C.P.; Bitton, G. The molecular mechanisms of copper and silver ion disinfection of bacteria and viruses. Crit. Rev. Environ. Sci. Technol. 1988, 18, 295–315. [Google Scholar] [CrossRef]
- Imlay, J.A. Pathways of oxidative damage. Annu. Rev. Microbiol. 2003, 57, 395–418. [Google Scholar] [CrossRef] [PubMed]
- Pramanik, A.; Laha, D.; Bhattacharya, D.; Pramanik, P.; Karmakar, P. A novel study of antibacterial activity of copper iodide nanoparticle mediated by DNA and membrane damage. Colloids Surf. B 2012, 96, 50–55. [Google Scholar] [CrossRef]
- Wang, L.; Hu, C.; Shao, L. The antimicrobial activity of nanoparticles: Present situation and prospects for the future. Int. J. Nanomed. 2017, 12, 1227–1249. [Google Scholar] [CrossRef]
- Alven, S.; Peter, S.; Mbese, Z.; Aderibigbe, B.A. Polymer-Based Wound Dressing Materials Loaded with Bioactive Agents: Potential Materials for the Treatment of Diabetic Wounds. Polym. J. 2022, 14, 724. [Google Scholar] [CrossRef] [PubMed]
- Pal, G.; Rai, P.; Pandey, A. Chapter 1—Green synthesis of nanoparticles: A greener approach for a cleaner future. In Green Synthesis, Characterization and Applications of Nanoparticles; Shukla, A.K., Iravani, S., Eds.; Elsevier: Amsterdam, The Netherlands, 2019; pp. 1–26. [Google Scholar] [CrossRef]
- Badhani, B.; Sharma, N.; Kakkar, R. Gallic acid: A versatile antioxidant with promising therapeutic and industrial applications. RSC Adv. 2015, 5, 27540–27557. [Google Scholar] [CrossRef]
- Khan, M.; Ahmad, F.; Koivisto, J.T.; Kellomäki, M. Green synthesis of controlled size gold and silver nanoparticles using antioxidant as capping and reducing agent. Colloid Interface Sci. Commun. 2020, 39, 100322. [Google Scholar] [CrossRef]
- Singh, J.; Dutta, T.; Kim, K.-H.; Rawat, M.; Samddar, P.; Kumar, P. ‘Green’ synthesis of metals and their oxide nanoparticles: Applications for environmental remediation. J. Nanobiotechnol. 2018, 16, 84. [Google Scholar] [CrossRef]
- Amini, S.M.; Akbari, A. Metal nanoparticles synthesis through natural phenolic acids. IET Nanobiotechnol. 2019, 13, 771–777. [Google Scholar] [CrossRef] [PubMed]
- Archana, K.M.; Yogalakshmi, D.; Rajagopal, R. Application of green synthesized nanocrystalline CuI in the removal of aqueous Mn(VII) and Cr(VI) ions. SN Appl. Sci. 2019, 1, 522. [Google Scholar] [CrossRef]
- Byranvand, M.M.; Kharat, A.N. Triangular-like Cuprous Iodide Nanostructures: Green and Rapid Synthesis Using Sugar Beet Juice. Rom. J. Biochem. 2014, 51, 101–107. [Google Scholar]
- Haridas, M.; Srivastava, S.; Basu, J.K. Tunable variation of optical properties of polymer capped gold nanoparticles. Eur. Phys. J. D 2008, 49, 93–100. [Google Scholar] [CrossRef]
- Chinnakutti, K.K.; Panneerselvam, V.; Govindarajan, D.; Soman, A.K.; Parasuraman, K.; Thankaraj Salammal, S. Optoelectronic and electrochemical behaviour of γ-CuI thin films prepared by solid iodination process. Prog. Nat. Sci. Mater. Int. 2019, 29, 533–540. [Google Scholar] [CrossRef]
- Akhtar, F.Z.; Archana, K.M.; Krishnaswamy, V.G.; Rajagopal, R. Remediation of heavy metals (Cr, Zn) using physical, chemical and biological methods: A novel approach. SN Appl. Sci. 2020, 2, 267. [Google Scholar] [CrossRef]
- Yao, K.; Chen, P.; Zhang, Z.; Li, J.; Ai, R.; Ma, H.; Zhao, B.; Sun, G.; Wu, R.; Tang, X.; et al. Synthesis of ultrathin two-dimensional nanosheets and van der Waals heterostructures from non-layered γ-CuI. NPJ 2D Mater. Appl. 2018, 2, 16. [Google Scholar] [CrossRef]
- Das, P.E.; Abu-Yousef, I.A.; Majdalawieh, A.F.; Narasimhan, S.; Poltronieri, P. Green Synthesis of Encapsulated Copper Nanoparticles Using a Hydroalcoholic Extract of Moringa oleifera Leaves and Assessment of Their Antioxidant and Antimicrobial Activities. Molecules 2020, 25, 555. [Google Scholar] [CrossRef]
- Selvamani, V. Chapter 15—Stability Studies on Nanomaterials Used in Drugs. In Characterization and Biology of Nanomaterials for Drug Delivery; Mohapatra, S.S., Ranjan, S., Dasgupta, N., Mishra, R.K., Thomas, S., Eds.; Elsevier: Amsterdam, The Netherlands, 2019; pp. 425–444. [Google Scholar] [CrossRef]
- Sun, X.; Dong, M.; Guo, Z.; Zhang, H.; Wang, J.; Jia, P.; Bu, T.; Liu, Y.; Li, L.; Wang, L. Multifunctional chitosan-copper-gallic acid based antibacterial nanocomposite wound dressing. Int. J. Biol. Macromol. 2021, 167, 10–22. [Google Scholar] [CrossRef]
- Slavin, Y.N.; Asnis, J.; Häfeli, U.O.; Bach, H. Metal nanoparticles: Understanding the mechanisms behind antibacterial activity. J. Nanobiotechnol. 2017, 15, 65. [Google Scholar] [CrossRef]
- Kharazmi, A.; Faraji, N.; Mat Hussin, R.; Saion, E.; Yunus, W.M.; Behzad, K. Structural, optical, opto-thermal and thermal properties of ZnS-PVA nanofluids synthesized through a radiolytic approach. Beilstein J. Nanotechnol. 2015, 6, 529–536. [Google Scholar] [CrossRef]
- Zeimaran, E.; Pourshahrestani, S.; Pingguan-Murphy, B.; Kadri, N.A.; Rothan, H.A.; Yusof, R.; Towler, M.R.; Djordjevic, I. Fabrication and characterization of poly(octanediol citrate)/gallium-containing bioglass microcomposite scaffolds. J. Mater. Sci. 2015, 50, 2189–2201. [Google Scholar] [CrossRef]
- Liu, J.; Zheng, X.J.; Tang, K. Study on the Gravimetric Measurement of the Swelling Behaviors of Polymer Films. Rev. Adv. Mater. Sci. 2013, 33, 452–458. [Google Scholar]
- Shahi, N.; Joshi, G.; Min, B. Effect of Regenerated Cellulose Fibers Derived from Black Oat on Functional Properties of PVA-Based Biocomposite Film. Processes 2020, 8, 1149. [Google Scholar] [CrossRef]
- Wen, Y.-H.; Tsou, C.-H.; de Guzman, M.R.; Huang, D.; Yu, Y.-Q.; Gao, C.; Zhang, X.-M.; Du, J.; Zheng, Y.-T.; Zhu, H.; et al. Antibacterial nanocomposite films of poly(vinyl alcohol) modified with zinc oxide-doped multiwalled carbon nanotubes as food packaging. Polym. Bull. 2022, 79, 3847–3866. [Google Scholar] [CrossRef]
- Abdullah, Z.W.; Dong, Y.; Han, N.; Liu, S. Water and gas barrier properties of polyvinyl alcohol (PVA)/starch (ST)/ glycerol (GL)/halloysite nanotube (HNT) bionanocomposite films: Experimental characterisation and modelling approach. Compos. B Eng. 2019, 174, 107033. [Google Scholar] [CrossRef]
- Nooeaid, P.; Chuysinuan, P.; Pengsuk, C.; Dechtrirat, D.; Lirdprapamongkol, K.; Techasakul, S.; Svasti, J. Polylactic acid microparticles embedded porous gelatin scaffolds with multifunctional properties for soft tissue engineering. J. Sci. Adv. Mater. Dev. 2020, 5, 337–345. [Google Scholar] [CrossRef]
- Zurdo Schroeder, I.; Franke, P.; Schaefer, U.F.; Lehr, C.M. Development and characterization of film forming polymeric solutions for skin drug delivery. Eur. J. Pharm. Biopharm. 2007, 65, 111–121. [Google Scholar] [CrossRef] [PubMed]

| Sample | Gallic Acid (GA) Contents (mM) | Zeta Potential (mV) | Average Value (mV) |
|---|---|---|---|
| CuI | 0 | −13.3 | −13.47 |
| −13.6 | |||
| −13.5 | |||
| 2.5 GA-CuI | 2.5 | −18.8 | −18.73 |
| −18.6 | |||
| −18.8 | |||
| 5.0 GA-CuI | 5 | −20.7 | −20.47 |
| −19.8 | |||
| −20.9 |
| CuI Sample | Gallic Acid Concentration (mM) | MIC (mg/mL) | MBC (mg/mL) | ||
|---|---|---|---|---|---|
| E. coli (−) | MRSA (+) | E. coli (−) | MRSA (+) | ||
| CuI | 0 | 8 | 16 | 32 | 32 |
| 2.5 GA-CuI | 2.5 | 16 | 32 | 64 | 32 |
| 5.0 GA-CuI | 5.0 | 16 | 32 | 64 | 32 |
| Assignment | Observed Wavelength (cm−1) | |||
|---|---|---|---|---|
| Pure PVA | PVA/CuI (0.095%) | PVA/CuI (0.190%) | Reference | |
| OH stretching | 3268.62 | 3328.42 | 3299.37 | [34] |
| Asymmetric stretching of CH2 | 2940.72 | 2940.72 | 2941.86 | [34] |
| Symmetric stretching of CH2 | 2911.56 | 2911.56 | - | [34] |
| C=O carbonyl stretching | 1653.96 | 1703.27 | 1698.17 | [34] |
| CH2 scissoring | - | 1447.77 | 1444.98 | [34] |
| CH2 bending | 1414.07 | 1419.38 | 1414.05 | [34] |
| CH2 wagging | 1328.07 | 1317.24 | - | [34] |
| C-OH stretching in alcohol | 1236.24 | 1239.7 | 1234.42 | [34] |
| C-O stretching | 1090.47 | 1088.07 | 1090.16 | [34] |
| Stretching of C=O and bending of OH | 1039.52 | 1042.26 | 1042.96 | [34] |
| C-C stretching | 842.91 | 796.64 | 797.43 | [34] |
Disclaimer/Publisher’s Note: The statements, opinions and data contained in all publications are solely those of the individual author(s) and contributor(s) and not of MDPI and/or the editor(s). MDPI and/or the editor(s) disclaim responsibility for any injury to people or property resulting from any ideas, methods, instructions or products referred to in the content. |
© 2023 by the authors. Licensee MDPI, Basel, Switzerland. This article is an open access article distributed under the terms and conditions of the Creative Commons Attribution (CC BY) license (https://creativecommons.org/licenses/by/4.0/).
Share and Cite
Phetcharat, P.; Sangsanoh, P.; Choipang, C.; Chaiarwut, S.; Suwantong, O.; Chuysinuan, P.; Supaphol, P. Curative Effects of Copper Iodide Embedded on Gallic Acid Incorporated in a Poly(vinyl alcohol) (PVA) Liquid Bandage. Gels 2023, 9, 53. https://doi.org/10.3390/gels9010053
Phetcharat P, Sangsanoh P, Choipang C, Chaiarwut S, Suwantong O, Chuysinuan P, Supaphol P. Curative Effects of Copper Iodide Embedded on Gallic Acid Incorporated in a Poly(vinyl alcohol) (PVA) Liquid Bandage. Gels. 2023; 9(1):53. https://doi.org/10.3390/gels9010053
Chicago/Turabian StylePhetcharat, Putita, Pakakrong Sangsanoh, Chasuda Choipang, Sonthaya Chaiarwut, Orawan Suwantong, Piyachat Chuysinuan, and Pitt Supaphol. 2023. "Curative Effects of Copper Iodide Embedded on Gallic Acid Incorporated in a Poly(vinyl alcohol) (PVA) Liquid Bandage" Gels 9, no. 1: 53. https://doi.org/10.3390/gels9010053
APA StylePhetcharat, P., Sangsanoh, P., Choipang, C., Chaiarwut, S., Suwantong, O., Chuysinuan, P., & Supaphol, P. (2023). Curative Effects of Copper Iodide Embedded on Gallic Acid Incorporated in a Poly(vinyl alcohol) (PVA) Liquid Bandage. Gels, 9(1), 53. https://doi.org/10.3390/gels9010053

